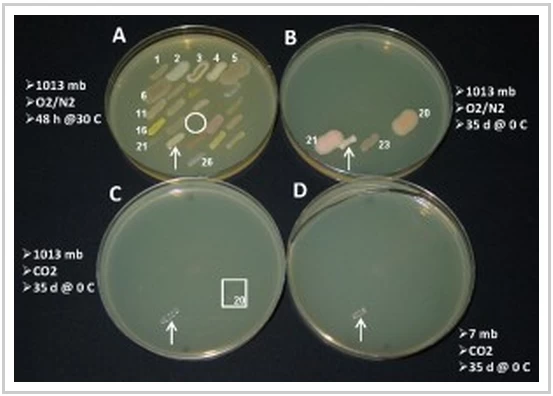

一項新研究表明,一種存在於從人類皮膚到植物根係等各種環境中的頑強細菌能夠在類似火星的環境中生存。這項發現對地外生命具有重要意義,但或許更重要的是,它對行星保護也具有重要意義。這些「搭便車」的微生物會不會從火星探測車「好奇號」(或其後代)上跳下來,並在這顆紅色星球上創造新的生命呢?
天體生物學家喜歡研究極端微生物,也就是那些生活在極端溫度或壓力下的細菌和其他生物,因為它們有可能在其他星球的惡劣環境中生存。但如作者所描述的,液化沙雷氏菌是一種適應性很強的微生物──它可能起源於海平面,如今卻生活在植物、動物和水生環境中。
為了了解未來人類任務可能將我們這些「骯髒」的生命形式帶到火星上會對火星造成多大危害,佛羅裡達大學的安德魯舒爾格領導的微生物學家團隊著手測試地球上常見的細菌在類似火星的環境中生存的能力。作者在本週發表於《天體生物學》雜誌上的論文中指出,這方面的數據出奇地匱乏。
他們研究了22種細菌的26個菌株,這些菌株先前都曾從太空船中回收,因此最有可能搭乘「太空船」抵達火星上適宜生存的區域。重要的是,研究人員假設這些細菌能夠承受旅途中可能遇到的有害輻射——即便如此,這項研究仍然有一些重要的發現。
研究團隊在培養皿中培養細菌菌落,然後降低溫度、壓力和氧氣濃度。高壓氧艙將大氣壓力降低至僅7毫巴,隨著環境條件的惡化,許多菌株死亡。 (地球大氣壓力約為1000毫巴。)液化沙雷氏菌(S. liquefaciens )能夠在7毫巴、冰凍溫度、低氧和高二氧化碳濃度的條件下生存——這與火星上的環境非常相似。有趣的是,兩種已知的極端微生物物種卻未能存活下來。
在另一項研究中,舒爾格及其同事分析了從西伯利亞永久凍土層40至70英尺深的岩芯樣本中回收的數千株細菌。他們認為,這些微生物或許能在火星的永凍土區中生存,而這區域可能成為未來尋找生命任務的理想目標。在這些樣本中,有六種細菌——全部屬於嗜冷菌屬(Carnobacterium)——在類似火星的環境中存活下來並持續生長。該研究於12月24日發表在《美國國家科學院院刊》(PNAS) 。
作者警告說,這些研究並不能證明生命可以在火星上生長。輻射危害是阻止太空船偷渡者在火星上定居的主要因素之一。但即便如此,這些細菌的頑強生命力——尤其是其中一種先前不被認為是極端微生物的細菌——表明,我們需要進行更多研究來嘗試解答這個問題。
